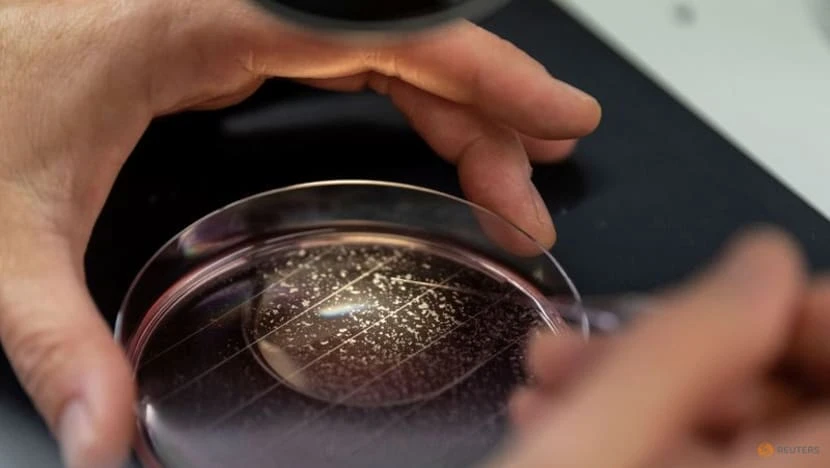

Theo hãng tin Reuters, một nhóm các nhà khoa học ở Đức đang nghiên cứu quá trình nhân bản và sau đó nhân giống lợn biến đổi gen trong năm nay để phục vụ cho việc lấy tim và cấy ghép cho con người.
Ông Eckhard Wolf, nhà khoa học tại ĐH Ludwig-Maximilians ở Munich, cho biết nhóm của ông đặt mục tiêu sẽ lai tạo thành công một giống loài lợn mới, được sửa đổi gene từ giống lợn đảo Auckland, và sẽ sẵn sàng cho các thử nghiệm cấy ghép tim vào năm 2025.

Hai chú lợn đứng trong chuồng tại một trang trại thử nghiệm ở Đức, ngày 24-1. Ảnh: REUTERS
Trước đó, vào tháng 1, một nhóm nghiên cứu tại ĐH Y Maryland (Mỹ) đã cấy ghép thành công quả tim của một con lợn có 10 lần chỉnh sửa gen vào một người đàn ông bị bệnh nan y, là ca phẫu thuật đưa tim lợn đầu tiên cho người.
Các bác sĩ của người đàn ông này cho biết hiện mọi thứ đang phản ứng tốt và sức khỏe của ông ấy vẫn ổng định, tuy vậy nguy cơ nhiễm trùng, đào thải nội tạng hoặc huyết áp cao vẫn còn.

Một con lợn đứng trong chuồng cùng một thành viên nhóm nghiên cứu tại trang trại thử nghiệm ở Oberschleissheim, Đức, ngày 24-1. Ảnh: REUTERS
Dựa trên những dữ liệu có được từ ca cấy ghép ở Mỹ, ông Wolf cho biết “kế hoạch của nhóm ông là “tiến hành một mô hình đơn giản hơn, cụ thể là với năm lần chỉnh sửa gen”.
Dành suốt 20 năm để nghiên cứu quá trình cấy ghép nội tạng động vật sang người, ông Wolf cho hay nhóm của ông sẽ sử dụng công nghệ nhân bản với mức độ hiệu quả thấp để chỉ tạo ra "thế hệ nguyên bản", từ đó tiến hành biến đổi di truyền và lai tạo, tạo nên các thế hệ mới trong tương lai.
Một thành viên nhóm nghiên cứu đang phân loại tế bào trứng từ lợn tại trang trại thử nghiệm ở Oberschleissheim, Đức, ngày 24-1. Ảnh: REUTERS
Thế hệ đầu tiên như vậy sẽ ra đời trong năm nay, và tim của chúng sẽ được thử nghiệm trên khỉ đầu chó trước khi nhóm nghiên cứu có được sự chấp thuận của chính quyền cho một cuộc thử nghiệm lâm sàng trên người trong thời gian hai hoặc ba năm tới.
Việc cấy ghép sẽ được áp dụng cho những người được chẩn đoán suy nội tạng mà không có phương hướng điều trị nào khác. Hiện có khoảng 8.500 người ở Đức đang đợi để được cấy ghép nội tạng, theo dữ liệu từ Tổ chức Cấy ghép Nội tạng của nước này vào cuối năm 2021.

Một thành viên nhóm nghiên cứu sử dụng một ống tiêm để lấy noãn từ buồng trứng của lợn. Ảnh: REUTERS
Bên cạnh những người ủng hộ nghiên cứu của ông Wolf, những người phản đối cho rằng công nghệ này đang xâm phạm quyền của động vật, biến loài lợn thành nạn nhân của các nhà thu gom nội tạng, trong khi những con khỉ được sử dụng trong các thí nghiệm cấy ghép thì chết trong đau đớn.
Trước đó, vào tháng 2-2019, một bản kiến nghị của nhóm những người phản đối việc thí nghiệm trên động vật yêu cầu lệnh cấm đối với nghiên cứu cấy ghép nội tạng đã thu thập được hơn 57.000 chữ ký.

Ông Eckhard Wolf, nhà nghiên cứu tại ĐH Ludwig-Maximilians ở Munich, Đức chụp ảnh tại trang trại thử nghiệm ở Oberschleissheim, Đức, ngày 24-1. Ảnh: REUTERS
Bà Kristina Berchtold, người phát ngôn của Hiệp hội Phúc lợi Động vật của Đức, chi nhánh Munich, cho rằng cuộc nghiên cứu này là "rất đáng nghi vấn về mặt đạo đức".
“Động vật không nên được dùng làm phụ tùng thay thế cho con người. Bất kỳ loài động vật nào, dù là một bản sao hay một con vật sinh ra tự nhiên đều có nhu cầu, nỗi sợ hãi và quyền lợi như nhau” - bà Berchtold nhấn mạnh.



































